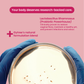

Fresh
Vaginal odour

Thriving
microbiome

Healthy
pH

Urinary tract
wellness




FAQ
Click on the link
It’s a daily probiotic + plant-based supplement designed to support vaginal pH balance, reduce odour, and prevent infections and helps in keeping your intimate area healthy, hydrated, and happy.
Vaginal pH, Vaginal Odour and Vaginal Flora
Your vaginal health depends on a delicate balance of good bacteria (vaginal flora) and pH levels. Stress, hormonal changes, or even antibiotics can disturb that balance. This capsule restores it, naturally.
It combines probiotics (Lactobacillus rhamnosus) with botanical extracts like Fenugreek, and Chasteberry to rebalance your internal microbiome, improve vaginal hydration and moisture, and support hormone health.
✔ Balances vaginal pH
✔ Prevents odour and infections
✔ Eases dryness and discomfort
✔ Supports hormonal harmony
✔ Promotes overall intimate well-being
Any woman aged 18 and above experiencing vaginal dryness, odour, discomfort, or simply wanting to maintain daily intimate balance and freshness.
Yes. It’s made for daily use, just one capsule a day helps maintain consistent balance and protection.
Take one capsule daily after a meal with water. Consistency is key for visible results.
Most women notice improvements in odour, freshness, and comfort within 3 to 4 weeks of regular use.
Absolutely. It’s 100% natural, non-GMO, gluten-free, and vegetarian. It is considered safe for long-term, hormone-friendly use.
It includes Vitex Agnus-Castus (Chasteberry), Fenugreek, Shatavari, Magnesium, Hyaluronic Acid, Saffron, Vitamin B6, Zinc, and Lactobacillus rhamnosus all known for their women’s health benefits. Full ingredient list is below.
Yes. It doesn’t contain any synthetic hormones. Instead, it helps your body naturally regulate its hormonal balance through herbs and nutrients.
Generally, yes. But if you’re on prescribed medication or antibiotics, it’s always best to consult your doctor before starting any new supplement.
Yes. It supports women across all life stages—from menstruation to perimenopause and menopause by restoring flora, hydration, and comfort.
It’s formulated specifically for vaginal and hormonal health, not just gut health. It’s also powered by science-backed botanicals that target women’s unique needs.
Links to clinical trials for probiotic
You can purchase it exclusively on shop.gytree.com
or via Amazon and other platforms.
Vitex Agnus-Castus Linn (Cranberry) Extract, Magnesium Citrate, Trigonella-Foenum-Graecum (Fenugreek) – Seeds Extract, Asparagus Densiflorus (Shatavari) Extract, L-Theanine, Hyaluronic Acid, Crocus Sativus L. (Saffron) Stigma Extract, Binder (INS 1201), Zinc Gluconate, Pyridoxine Hydrochloride, Lactobacillus Rhamnosus, Veg. Capsule Shell.